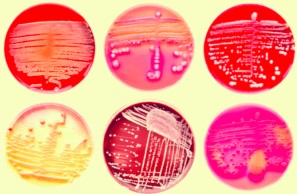
imatge-resistències

Les infeccions per Staphylococcus aureus són particularment problemàtiques per l’elevat nombre de casos aïllats que presenten resistència a algun antibiòtic (RA), d’entre els quals cal destacar les soques de S. aureus que presenten resistència a la meticil·lina (SARM).
La Subdirecció General de Vigilància i Resposta a Emergències de Salut Pública de l’Agència de Salut Pública de Catalunya ha publicat l’informe Anàlisi de la sensibilitat als antimicrobians de Staphylococcus aureus: Catalunya 2020–2024, on s’analitza l’evolució de la sensibilitat antibiòtica de les soques invasives de S. aureus sensibles a la meticil·lina (SASM) i resistents a la meticil·lina (SARM).
L’informe inclou:
- La sensibilitat antibiòtica de 9.994 soques invasives de S. aureus notificades de manera continuada pels diferents centres participants en el Sistema de Notificació Microbiològica de Catalunya.
- D’aquest total, 8.102 (81,1%) corresponen a SASM i 1.892 (18,9%) a SARM.
- Aquesta proporció de SASM-SARM s’ha mantingut estable al llarg del període analitzat.
Així doncs, la taxa d’incidència per cada 100.000 habitants ha estat de:
- 23,0 casos de SASM, incidència per sota de les dades europees disponibles (30,7 i 32,3 casos el 2022 i el 2023, respectivament).
- 5,6 casos de SARM, incidència lleugerament superior a la d’Espanya i Europa el 2023 (4,3 i 4,6 casos, respectivament).
En referència a l’anàlisi de les soques de SASM s’ha observat:
- Un 70% de soques resistents a la benzilpenicil·lina en l’any 2024, mostrant una reducció del 85,8% respecte l’any 2020 (Figura 1).
Quant a l’estudi de la resistència de les soques de SARM s’ha detectat:
- El 100% de les soques han resultat resistents a la benzilpenicil·lina.
- Les resistències a les quinolones es mantenen elevades, amb un 76,6% a la ciprofloxacina i un 74,4% a la levofloxacina; tanmateix, s’observa un descens significatiu entre 2020 i 2024.
- En referència als aminoglicòsids, un 15,9% de les soques són resistents a la gentamicina i un 47,2% a la tobramicina. La resta d’antibiòtics es poden consultar a la figura 1.

L’Organització Mundial de la Salut considera les RA una de les principals preocupacions en salut pública i, per tant, estableix com a prioritària la recerca urgent de noves opcions terapèutiques per fer front a aquests bacteris.
A Catalunya, la vigilància de les RA es coordina des de l’SGVRESP a través del Sistema de notificació microbiològica de Catalunya i la notificació de les RA és de compliment obligat (Decret 203/2015).
Per a més informació




 Contacte
Contacte

